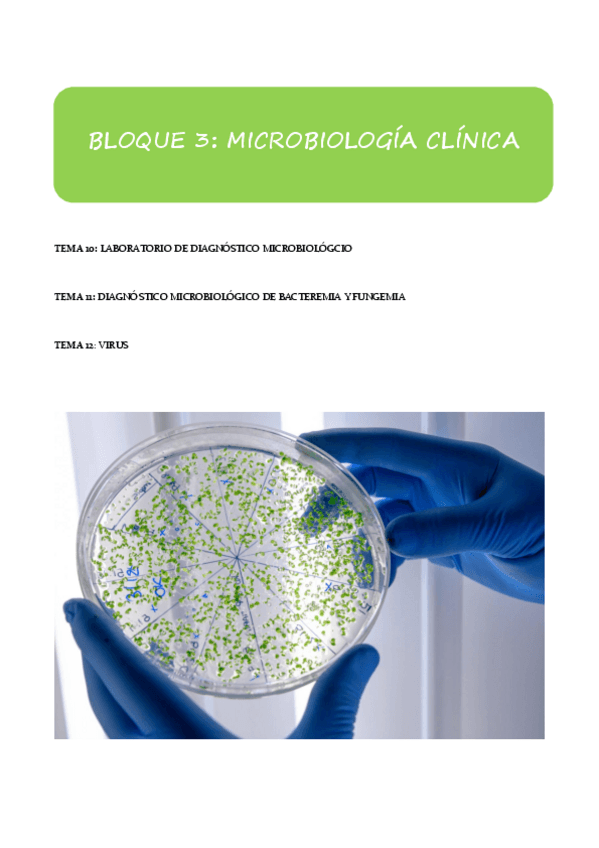

Diagnóstico Biológico
apuntes
-
Temas 1-13
He publicado nuevos apuntes de 4º Diagnóstico Biológico: Temas 1-13
He publicado nuevos examenes de 4º Diagnóstico Biológico: Preguntas-diagnostico-pdf.pdf
He publicado nuevos examenes de 4º Diagnóstico Biológico: Preguntas-de-repaso-de-diagnostico.pdf
He publicado nuevos examenes de 4º Diagnóstico Biológico: EXAMEN-DIAGNOSTICO.pdf
He publicado nuevos examenes de 4º Diagnóstico Biológico: Diagnostico-biologico.pdf
He publicado nuevos examenes de 4º Diagnóstico Biológico: Diagnostico-biologico-examen.pdf
He publicado nuevos examenes de 4º Diagnóstico Biológico: Diagnostico-biologico.pdf
apuntes
-
DIAGNÓSTICO MICROBIOLÓGICO DE LA BACTERIEMIA Y LA FUNGEMIA
He publicado nuevos apuntes de 4º Diagnóstico Biológico: DIAGNÓSTICO MICROBIOLÓGICO DE LA BACTERIEMIA Y LA FUNGEMIA

¡Estás al día!
Has visto todos los archivos